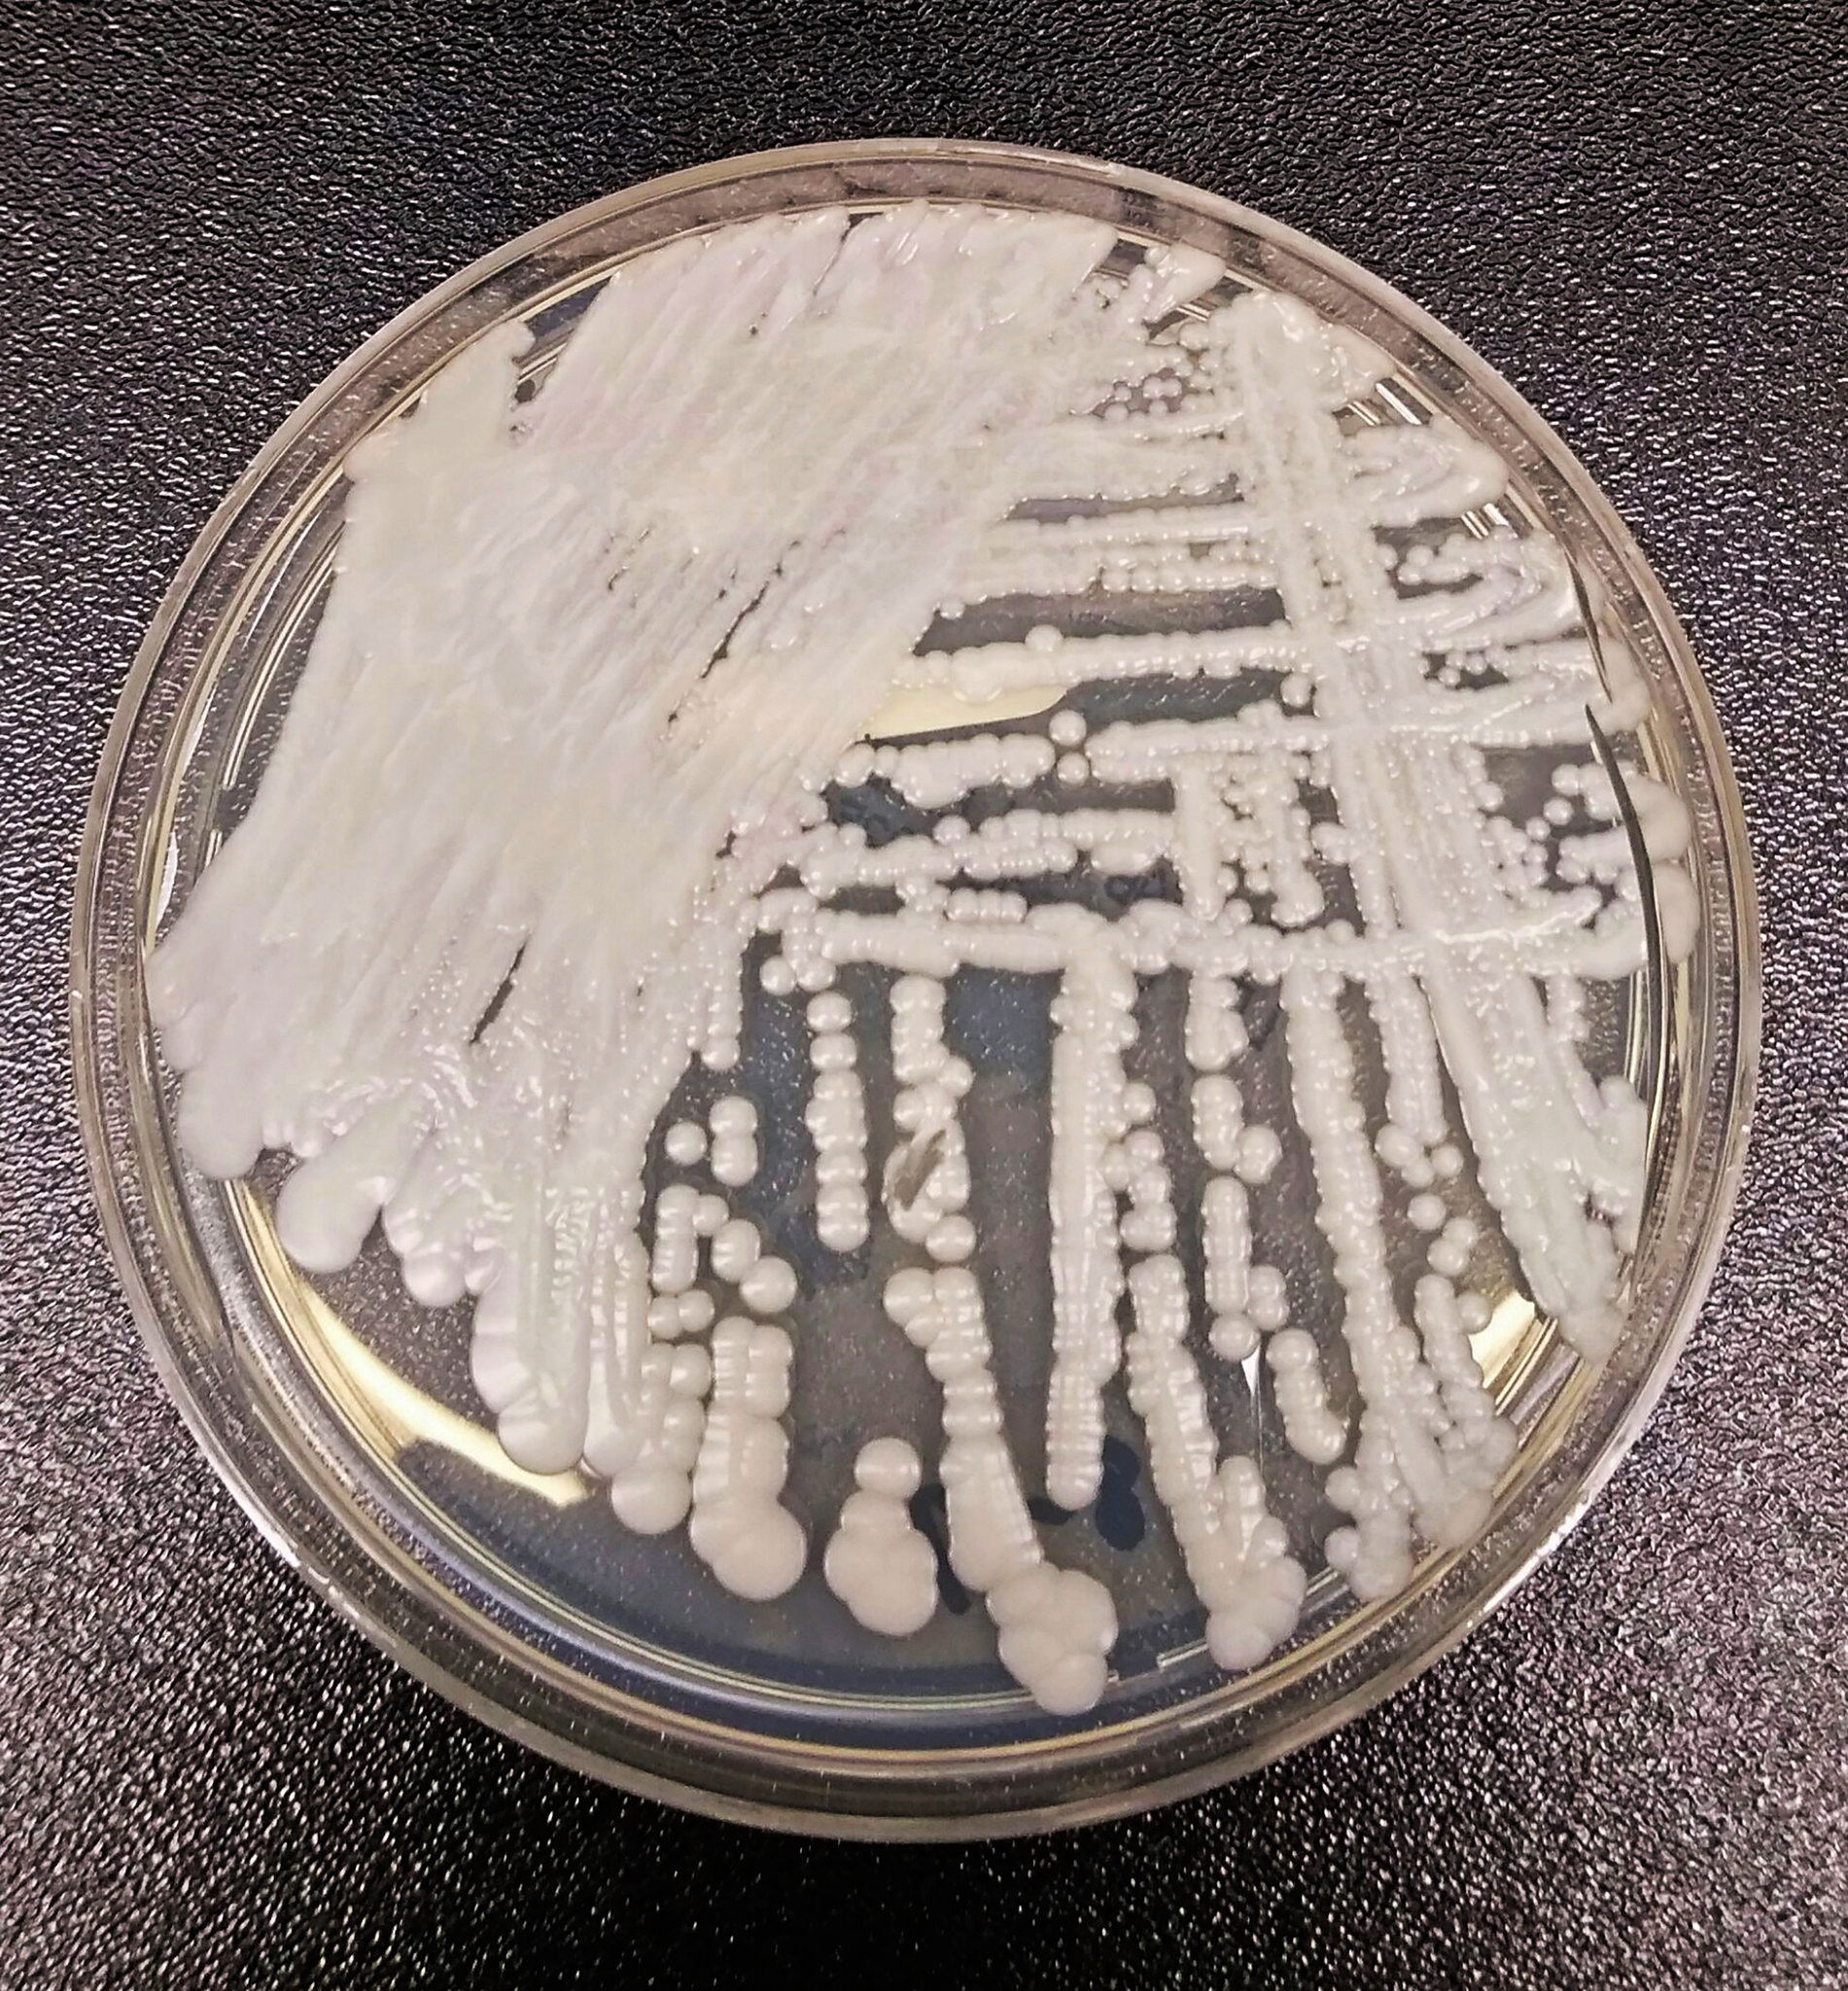
merlin_153106551_4892c691-0e7b-46e2-a9cc-1613f8638141-superjumbo.jpg

NY Times: Θανατηφόρο μικρόβιο εξαπλώνεται παγκοσμίως
Το δημοσίευμα αναφέρει πως παρατηρείται μια περίεργη ησυχία γύρω από το συγκεκριμένο θέμα🕛 χρόνος ανάγνωσης: 3 λεπτά ┋

Ένα είδος μικροβίου που ονομάζεται Candida Auris αποτελεί σημαντικό κίνδυνο για τη δημόσια υγεία και εξαπλώνεται σε όλο τον κόσμο, σύμφωνα με τους New York Times. Το δημοσίευμα, μάλιστα, αναφέρει πως παρατηρείται μια περίεργη ησυχία γύρω από το συγκεκριμένο θέμα.
Ένας ηλικιωμένος άνδρας μεταφέρθηκε τον περασμένο Μάιο σε νοσοκομείο του Μπρούκλιν της Νέας Υόρκης με έντονους πόνους στην κοιλιά. Οι εξετάσεις αίματος έδειξαν ότι είχε μολυνθεί από ένα μυστηριώδες αλλά και θανατηφόρο μικρόβιο, γι' αυτό απομονώθηκε στη μονάδα εντατικής θεραπείας. Οι έρευνες αποκάλυψαν ότι είχε προσβληθεί από έναν μύκητα που ονομάζεται Candida Auris, ο οποίος επιτίθεται σε ανθρώπους με αδύναμο ανοσοποιητικό σύστημα.
Συνήθως, η μόλυνση συμβαίνει αφότου ο ασθενής έχει κλείσει αρκετές εβδομάδες νοσηλείας. Οι πιο συχνά αναφερόμενες λοιμώξεις έχουν βρεθεί σε τραύματα, αιμοφόρα αγγεία και αυτιά. Ο μύκητας έχει βρεθεί ακόμα και σε ούρα ασθενών και στις αναπνευστικές οδούς, ωστόσο δεν είναι σαφές εάν το μικρόβιο απλώς παραμένει σε αυτά τα σημεία χωρίς να προκαλεί πρόβλημα.
Το επικίνδυνο αυτό βακτήριο φαίνεται πως εξαπλώνεται σε όλο τον κόσμο. Τα τελευταία πέντε χρόνια το μικρόβιο βρέθηκε και σε μια μονάδα νεογνών της Βενεζουέλας, σ’ ένα νοσοκομείο της Ισπανίας, ενώ ανάγκασε ένα διάσημο βρετανικό ιατρικό κέντρο να κλείσει τη μονάδα εντατικής θεραπείας του. Εντοπίστηκε επίσης σε Ινδία, Πακιστάν και Νότια Αφρική.
Πρόσφατα φαίνεται πως το μικρόβιο εξαπλώθηκε και στις ΗΠΑ, καθώς εντοπίστηκε σε Νέα Υόρκη, Νιου Τζέρσεϊ και Ιλινόις. Οι Ομοσπονδιακές Αρχές Ελέγχου και Πρόληψης Νοσημάτων των ΗΠΑ το προσέθεσαν στη λίστα με τα μικρόβια που θεωρούνται «επείγουσες απειλές».
Σύμφωνα με τους Times, το στέλεχος του C. Αuris είναι ανθεκτικό, καθώς είναι αδιαπέραστο από μείζονες αντιμυκητιασικές φαρμακευτικές ουσίες, καθιστώντας το έτσι ως μία από τις πιο μεγάλες απειλές για την παγκόσμια υγεία.
Τι είναι ο μύκητας Candida Auris
Ο μύκητας Candida Auris μπορεί να παραμείνει για πολύ καιρό στο δέρμα ενός ανθρώπου, αλλά και σε άλλα αντικείμενα όπως τα έπιπλα του σπιτιού και ο εξοπλισμός του νοσοκομείου. Έτσι, μπορεί να εξαπλωθεί έμμεσα από ασθενή σε ασθενή.
Μπορεί να εισβάλει στο σώμα και να σκοτώσει τον ασθενή, εάν το ανοσοποιητικό του σύστημα έχει ήδη αποδυναμωθεί. Ο μύκητας Candida auris αποδεικνύεται πολύ ανθεκτικός στις τρεις κύριες κατηγορίες αντιμυκητιασιακών φαρμάκων, αφήνοντας τους γιατρούς με λίγες επιλογές για την θεραπεία των λοιμώξεων που προκαλεί.
Σκοτώνει σχεδόν τους μισούς ασθενείς που προσβάλλει
Μια έρευνας, που δημοσιεύθηκε πέρυσι στο επιστημονικό περιοδικό Emerging Infectious Diseases, έδειξε ότι σχεδόν το ήμισυ των ασθενών που μολύνθηκαν από τον μύκητα στις ΗΠΑ από το 2016 έως το 2018, πέθανε μέσα σε 90 ημέρες από τότε που διαγνώστηκε πως είχε προσβληθεί από το βακτήριο. Η μελέτη εξέτασε 51 περιστατικά ασθενών.
Όταν πραγματοποιήθηκε έλεγχος σε διάφορα αντικείμενα και άλλους χώρους των νοσοκομείων, διαπιστώθηκε ότι ο μύκητας είχε ευρύτερη παρουσία στα 15 από τα 20 συνολικά νοσοκομεία, που εξετάστηκαν.
Εξαγριωμένος επιβάτης κλώτσησε την αυτόματη πύλη αεροδρομίου, έχασε την πτήση και κατέληξε με χειροπέδες
Καλλιθέα: Βίντεο από τη στιγμή των πυροβολισμών στο μπαρ - Το βλέπουν και... συνεχίζουν να χορεύουν
Νέα τραγωδία με νεαρή γυναίκα: Νεκρή 24χρονη στον Πειραιά - Έπεσε από τον 7ο όροφο πολυκατοικίας
Βίντεο ντοκουμέντο: Κλέφτης γίνεται «καπνός» με μηχανάκι μέσα σε 12 δευτερόλεπτα στη Θεσσαλονίκη
Live όλες οι εξελίξεις λεπτό προς λεπτό, με την υπογραφή του www.ethnos.gr
δημοφιλές τώρα: 



